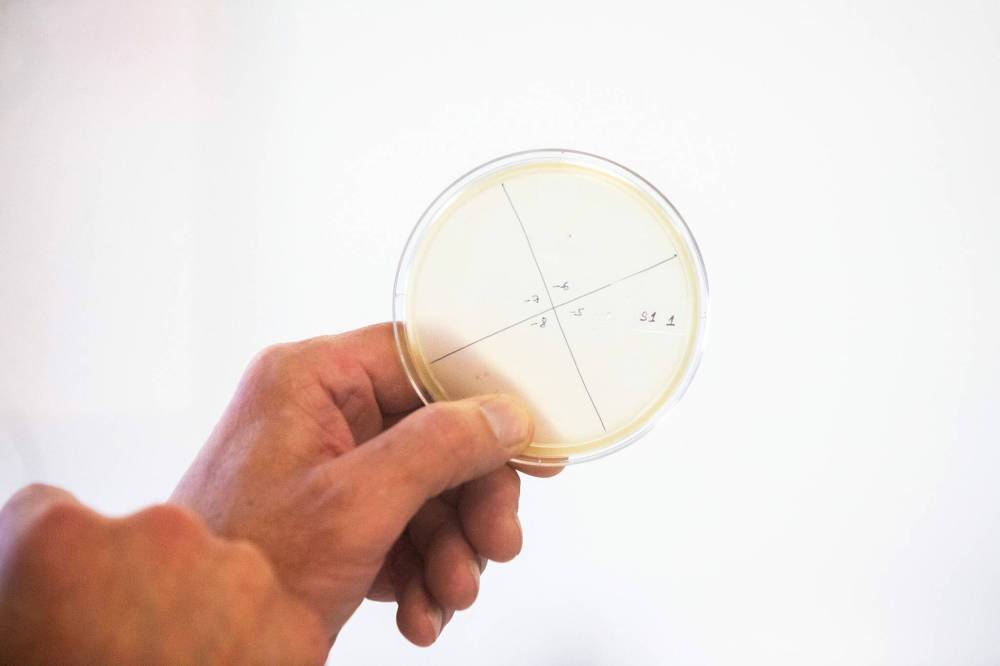

‘Space to expand’ antibacterial front line
Bioscience business Cytophage takes over former trampoline park building
Advertisement
Read this article for free:
or
Already have an account? Log in here »
To continue reading, please subscribe:
Monthly Digital Subscription
$1 per week for 24 weeks*
- Enjoy unlimited reading on winnipegfreepress.com
- Read the E-Edition, our digital replica newspaper
- Access News Break, our award-winning app
- Play interactive puzzles
*Billed as $4.00 plus GST every four weeks. After 24 weeks, price increases to the regular rate of $19.00 plus GST every four weeks. Offer available to new and qualified returning subscribers only. Cancel any time.
Monthly Digital Subscription
$4.75/week*
- Enjoy unlimited reading on winnipegfreepress.com
- Read the E-Edition, our digital replica newspaper
- Access News Break, our award-winning app
- Play interactive puzzles
*Billed as $19 plus GST every four weeks. Cancel any time.
To continue reading, please subscribe:
Add Free Press access to your Brandon Sun subscription for only an additional
$1 for the first 4 weeks*
*Your next subscription payment will increase by $1.00 and you will be charged $16.99 plus GST for four weeks. After four weeks, your payment will increase to $23.99 plus GST every four weeks.
Read unlimited articles for free today:
or
Already have an account? Log in here »
Hey there, time traveller!
This article was published 03/05/2024 (526 days ago), so information in it may no longer be current.
The only people bouncing around a former Winnipeg area trampoline park will be scientists in lab coats.
Bioscience business Cytophage is quadrupling its footprint by moving to the former Sky Zone location in the Rural Municipality of Macdonald.
The company seeks to reduce antibiotic use and prevent antimicrobial resistance. It transitioned to publicly traded from private in February; it hopes to soon sell products in Bangladesh.

MIKAELA MACKENZIE / FREE PRESS
Steven Theriault, CEO of Cytophage, in the company’s current labs on Henlow Bay in Winnipeg, says it is seeking to sell its products in Bangladesh first.
“We now have space to expand,” said Steven Theriault, Cytophage founder and chief executive.
He sat in a shared office on the southwest edge of Winnipeg. Cytophage holds two labs and 5,000 square feet in the building, where it tests phages, or viruses, of bacteria.
Phages kill specific bacteria after binding to them and inserting their own genetic information.
The viruses were discovered in the 1910s. After a decade, they took a backseat to antibiotics, which were more easily used and patentable.
Phages can’t blanketly kill bacteria. Part of Cytophage’s work is finding which combinations blend — meaning, which phages can kill which bacteria. Its staff also modifies phages.
They’re now using phages to replace antibiotic use in animals, to create disinfectant and, occasionally, treat human infections.
Theriault plans to conduct most business internationally until “Canada catches up,” adding complaints of being hamstrung by Health Canada regulations.
Cytophage’s late-May move from Henlow Bay to the former trampoline park building comes roughly eight years after the company’s formation. The Fort Whyte Way site is under renovation.
Once relocated, the team of roughly 16 scientists won’t need to squeeze by each other in their labs, Theriault noted.
The synthetic biologists, virologists and bacteriologists have worked on phage products — antibiotic replacements — to be consumed daily by chickens and other farm animals, Theriault said.
Some nations, including the European Union, have prohibited the use of antibiotics in farm animals. Overuse contributes to the rising threat of antibiotic resistance, the World Health Organization warns.
Canada implemented rules to reduce antibiotic use in 2018; livestock farmers now need veterinary prescriptions. Still, overuse is rampant, World Animal Protection Canada cautioned last year.
Cytophage makes liquid and freeze-dried phage products for animals to intake through their water. It’s been conducting tests in Bangladesh and will soon begin sales, Theriault relayed.
He isn’t rushing to sell at home. Registering the products will take many years, “a whole bunch of money and red tape,” he stated.
Health Canada didn’t answer questions by print deadline.
Last winter, Cytophage partnered with the Ottawa Hospital in treating Canada’s first phage therapy patient for a chronic artificial joint infection.
The infection had become resistant to many types of antibiotics. The hospital needed to “think outside the box,” according to a University of Ottawa news release.
Ottawa Hospital received approval from Health Canada for a single-patient clinical trial; phage therapy is experimental and can only be conducted in the country as such.
MACKENZIE / FREE PRESS
Cytophage works in phage therapy, seeking to reduce or replace antibiotic use.
It’s “pro bono” work and hurdle-laden for Cytophage, Theriault said. Still, he hopes to steer the company into human health treatment if regulations ease, he added.
“Sometimes, the patients, they don’t have enough time to wait for those (Health Canada) approvals,” said Tasia Lightly, a Cytophage staff scientist.
She pointed to Australia, which has a national network of phage researchers and scientists trying to professionalize phage therapy. The therapy requires a “boutique, compassionate care-type treatment,” Lightly said — every treatment is different.
“For me, phages aren’t about replacing antibiotics — we need antibiotics — but it’s about prolonging the use of them,” Lightly said. “(It’s) adding another tool to our toolbox to make sure that antibiotics are still able to work.”
Cytophage has also created a phage-based disinfectant to coat chicken eggs and remove bacterial contamination. (It will sell the product in Canada if it receives government approval, Theriault said.)
“I think Cytophage is creating a solution for a problem that a lot of us are either worried about or it’s impacting our lives directly,” said Andrea Ladouceur, president of the Bioscience Association of Manitoba.
She’s watched companies leave Canada — largely for the United States — because of long health-related regulatory processes, Ladouceur added.
“Canada is renowned for being really good in (regulation),” she continued. “But how do we do that more efficiently, so these companies can get to market quicker?”
Some Manitoba bioscience organizations who choose to stay in Canada leave the province because of a lack of lab space, Ladouceur said.
The Bioscience Association of Manitoba is working with the province and stakeholders to create “tangible solutions,” she said, adding a proposal is in the works.
Manitoba’s biosciences sector generates more than $5 billion in provincial GDP.
Cytophage has been fuelled by angel investment — upwards of $15 million over the past six years, according to Theriault.
He’s anticipating the company will be “cash neutral” in 2025, assuming sales in Bangladesh go as planned.
gabrielle.piche@winnipegfreepress.com

Gabrielle Piché reports on business for the Free Press. She interned at the Free Press and worked for its sister outlet, Canstar Community News, before entering the business beat in 2021. Read more about Gabrielle.
Every piece of reporting Gabrielle produces is reviewed by an editing team before it is posted online or published in print — part of the Free Press‘s tradition, since 1872, of producing reliable independent journalism. Read more about Free Press’s history and mandate, and learn how our newsroom operates.
Our newsroom depends on a growing audience of readers to power our journalism. If you are not a paid reader, please consider becoming a subscriber.
Our newsroom depends on its audience of readers to power our journalism. Thank you for your support.